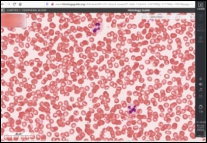

采取6+4教学模式 开展留学生线上教学
在新冠肺炎疫情防控期间,南华大学衡阳医学院组织学与胚胎学教研室的教师们针对留学生的特点,科学遴选教学平台,积极探索教学模式,建立了全英文《组织胚胎学》在线课程,努力保障教学效果,为达到线上线下教学质量“实质等效”的目标迈出了坚实步伐。
1.理论授课六步走
组织学与胚胎学是一门重要的医学基础课,属于形态学范畴,其线上教学受到了多方面因素的制约。例如在开课初期教师们先后尝试了“超星直播”和“雨课堂”等多个平台,但是发现学生无法看到老师鼠标所指的结构,不利于学生学习和掌握形态结构。经过多方面对比,教师们发现“腾讯课堂”和QQ屏幕分享的直播,可以弥补这一缺陷,于是使用腾讯课堂(极速版)进行直播授课。腾讯课堂授课可以充分发挥四个方面的功能:一是PPT授课功能;二是视频播放功能;三是屏幕共享功能;四是在讨论中输入文字与学生交流功能(图1)。此外,还可以音频开关按钮向学生播放教学音频。
腾讯课堂授课采取6个步骤。

图1. 腾讯课堂线上授课功能框架图(教师端)
第一步:调整授课时间。通过微信联系学生,沟通上课的具体时间。由于部分留学生在国外,与国内有时差,需适当调整线上授课时间(例如北京时间早上8:00,为印度时间5:30,与学生沟通后可将早上1-2节课调整到晚上9-10节)。
第二步:发放授课资料。通过微信提前给学生发放本次课的学习资料,如教材、授课PPT等。
第三步:落实学习签到。上课前通过“学习通”发放签到,并且在微信提醒学生及时签到;将腾讯课堂的二维码发给学生,要求学生在“学习通”签到后,用微信、QQ或腾讯课堂APP扫码进入课堂。因为腾讯课堂不一定是实名制,无法统计学生到课情况,所以签到在“学习通”进行。
第四步:开始课堂上课。在上课之前,开启生成回放功能,上课的录像会自动保存,方便未到课的学生学习,同时也方便学生课后再次学习。直播授课时,学生用手机进入课堂后,学生能与在教室听课一样,同步看到老师的PTT和听到讲解的声音(图2左和右)。针对课堂教学中的难点,教师通过分享屏幕,向学生展示在线的动画资源,同时配上语音直播讲解,帮助学生理解(图2中)。



图2 学生手机端界面
第五步:授课结束监督。在右上角下拉箭头导出听课学生名单,查看学生听课时长等详细信息,然后点击下课。
第六步:回放反复观看。腾讯课堂一般会在下课后24小时内生成回放。在24小时后,再次登陆腾讯课堂,点击“历史课程”,可以查看授课的回放录像。后期也可以将录像或者链接放到“超星”等线上平台,供学生反复观看和学习。
2.实验教学四环节
线下的组织学实验课是以学生自主观察组织切片为主,其目的是帮助学生学习和掌握人体的微细结构与功能。为了实现与线下实验教学等同的教学目标,老师们积极寻找优质的线上虚拟切片资源,充分利用腾讯课堂的互动教学功能开展线上实验课教学。经过反复的讨论和思考,确定了实验线上教学的四个环节:
课前交代实验内容:
实验课前通过腾讯课堂直播授课,交代每次实验的内容、目的要求及观察虚拟切片的注意事项(图3左)。交代过程中特别强调在切片中寻找典型的细胞和结构,便于学习和掌握实验内容。


图3 实验课交代和小结
学生观察虚拟数字切片:
教研室通过多方搜索、反复查阅,发掘了优质的线上虚拟切片平台资源。采用的虚拟切片平台是:http://www.histologyguide.org/slidebox/slideb ox.html(图4左)。每次课将需要观察的切片编号及链接发送给学生,以便学生自主观察学习;或者通过腾讯课堂分享屏幕,带学生一起观察,同时辅以语音讲解,在线解答学生在观察切片过程中的各种问题。

图4 虚拟切片教学网站界面
下课前小结实验内容:
通过腾讯课堂直播授课,归纳小结本次课的重点、难点;把本堂课看过的组织以图片的形式给学生进行辨认,通过提问了解学生对本堂课内容的掌握情况,提高学生的学习效果;下课前布置学生课后需要完成的实验报告(图3右)。
学生课后完成实验报告:
采用电子实验报告,要求学生将在线上虚拟切片中观察到的典型结构或细胞截图,在PPT中做好标注,通过电子邮件或者QQ发给任课老师;老师在课后进行批改,并在下次实验课前向学生反馈(图5)。

图5 留学生实验报告示例
到目前为止,全英文《组织学与胚胎学》课程的线上教学得到了很多留学生的青睐,学生到课率高,在线学习积极主动;学生们纷纷表示课程线上资源丰富,老师在线讲解清晰明了,学习效果非常理想。在新冠肺炎疫情防控期间,南华大学衡阳医学院组织胚胎学教研室的教师们仍在不断探索,优化线上教学模式,为进一步实现线上线下教学质量“实质等效”的教学目标继续努力。



图6 留学生在各自国家上网课


图7 线上教学情况留学生反馈

